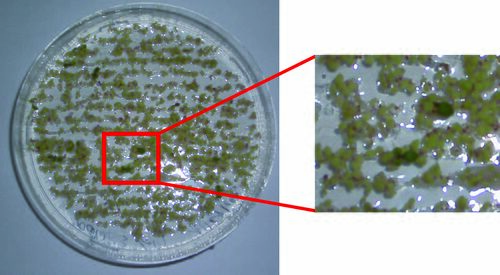

kanamycin selection of transgenic seeds
Selection of transformed Arabidopsis (Kanamycin Selection)
- Sterilize seeds and stratify them for 2 d at 4°C in the dark
- Sow seeds on ATS + 50 μg/ml Kanamycin
- Cultivate seedlings for 10 d at 20°C under LD conditions
Evaluation:
- transformed seedlings are resistant to Kanamycin and show green and open, expanded cotyledons
- untransformed seedlings are sensitive to Kanamycin and therefore cotyledons appear yellow and closed
|